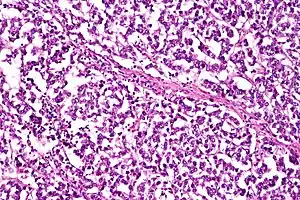

Dysgerminoma
A dysgerminoma is a type of germ cell tumor;[1] it usually is malignant and usually occurs in the ovary.
| Dysgerminoma | |
|---|---|
| |
| Micrograph of a dysgerminoma, H&E stain. | |
| Specialty | Oncology, gynecology |
A tumor of the identical histology but not occurring in the ovary may be described by an alternate name: seminoma in the testis[2] or germinoma in the central nervous system or other parts of the body.
Dysgerminoma accounts for less than 1% of ovarian tumors overall. Dysgerminoma usually occurs in adolescence and early adult life; about 5% occur in pre-pubertal children. Dysgerminoma is extremely rare after age 50. Dysgerminoma occurs in both ovaries in 10% of patients and, in a further 10%, there is microscopic tumor in the other ovary.
Abnormal gonads (due to gonadal dysgenesis and androgen insensitivity syndrome) have a high risk[3] of developing a dysgerminoma. Most dysgerminomas are associated with elevated serum lactic dehydrogenase (LDH), which is sometimes used as a tumor marker.
Signs and symptoms

They are exceptionally associated with hypercalcemia. On gross examination, dysgerminomas present with a smooth, bosselated (knobby) external surface, and is soft, fleshy and either cream-coloured, gray, pink or tan when cut. Microscopic examination typically reveals uniform cells that resemble primordial germ cells. Typically, the stroma contains lymphocytes and about 20% of patients have sarcoid-like granulomas. Metastases are most often present in the lymph nodes.
Diagnosis
LDH tumour markers is elevated in 95% of the cases.
Treatment
Dysgerminomas, like other seminomatous germ cell tumors, are very sensitive to both chemotherapy and radiotherapy. For this reason, with treatment patients' chances of long-term survival, even cure, is excellent.[4] Targeted treatments for dysgerminomas that do not respond to chemotherapy are being evaluated.[5]
References
- Behtash N, Karimi Zarchi M (2007). "Dysgerminoma in three patients with Swyer syndrome". World J Surg Oncol. 5 (1): 71. doi:10.1186/1477-7819-5-71. PMC 1934908. PMID 17587461.
- "dysgerminoma" at Dorland's Medical Dictionary
- Nelson Textbook of Pediatrics, 18th ed. Chapter 553. Question 11, Gynecologic Problems of Childhood
- Maoz, Asaf; Matsuo, Koji; Ciccone, Marcia A.; Matsuzaki, Shinya; Klar, Maximilian; Roman, Lynda D.; Sood, Anil K.; Gershenson, David M. (2020-05-29). "Molecular Pathways and Targeted Therapies for Malignant Ovarian Germ Cell Tumors and Sex Cord-Stromal Tumors: A Contemporary Review". Cancers. 12 (6). doi:10.3390/cancers12061398. ISSN 2072-6694. PMID 32485873.
- Maoz, Asaf; Matsuo, Koji; Ciccone, Marcia A.; Matsuzaki, Shinya; Klar, Maximilian; Roman, Lynda D.; Sood, Anil K.; Gershenson, David M. (2020-05-29). "Molecular Pathways and Targeted Therapies for Malignant Ovarian Germ Cell Tumors and Sex Cord-Stromal Tumors: A Contemporary Review". Cancers. 12 (6). doi:10.3390/cancers12061398. ISSN 2072-6694. PMID 32485873.

